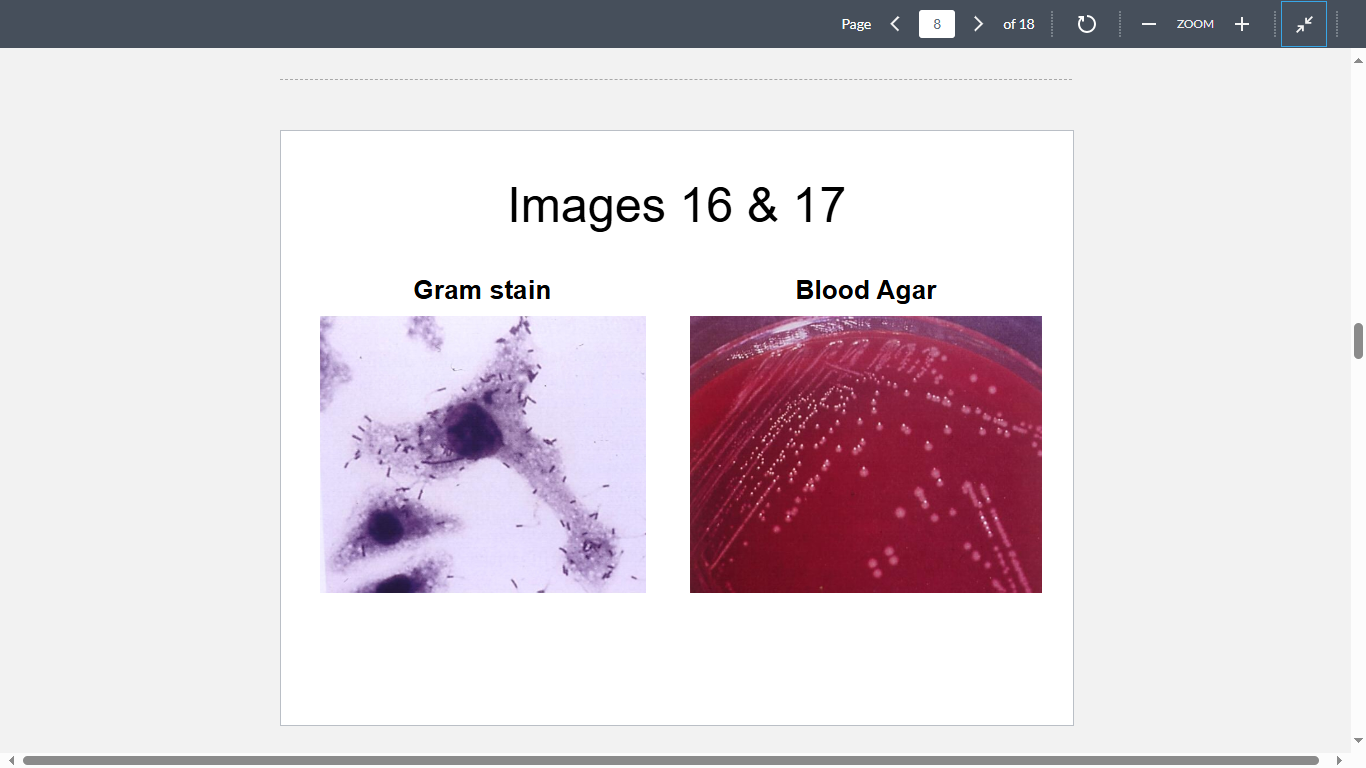
<p>A 27-year-old pregnant woman has developed meningitis shortly after drinking raw milk at her grandparents’ farm. Gram stain of her CSF shows these organisms (Image 16). Culture of the CSF yields an isolate (Image 17) that produces barely noticeable beta- hemolysis. The isolate is most likely to be</p>
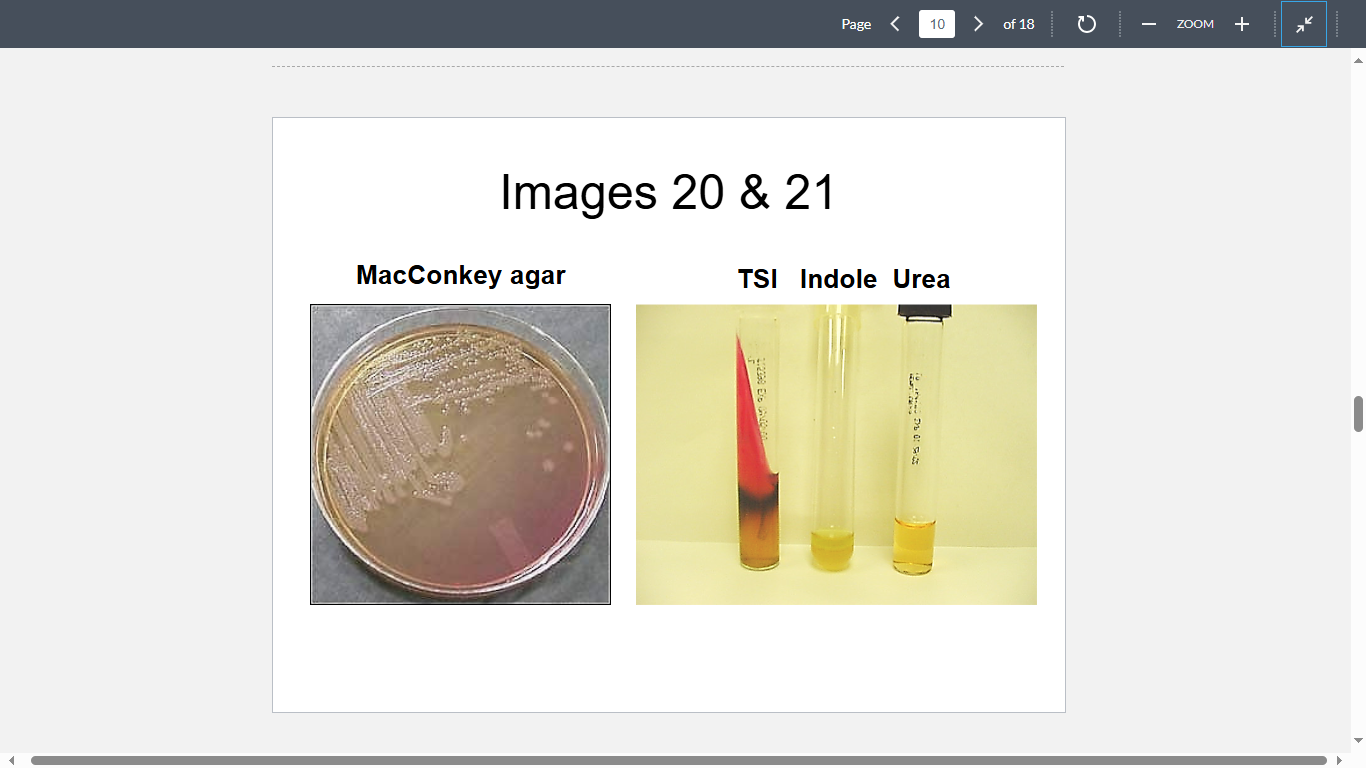
<p>A 47-year-old diabetic male has developed osteomyelitis of the fibula. Culture of a needle aspirate obtained from the infected bone yields these colonies on a MacConkey agar plate (Image 20). The isolate is subcultured on TSI, tryptone and urea containing media (Image 21). What is the most likely cause?</p>
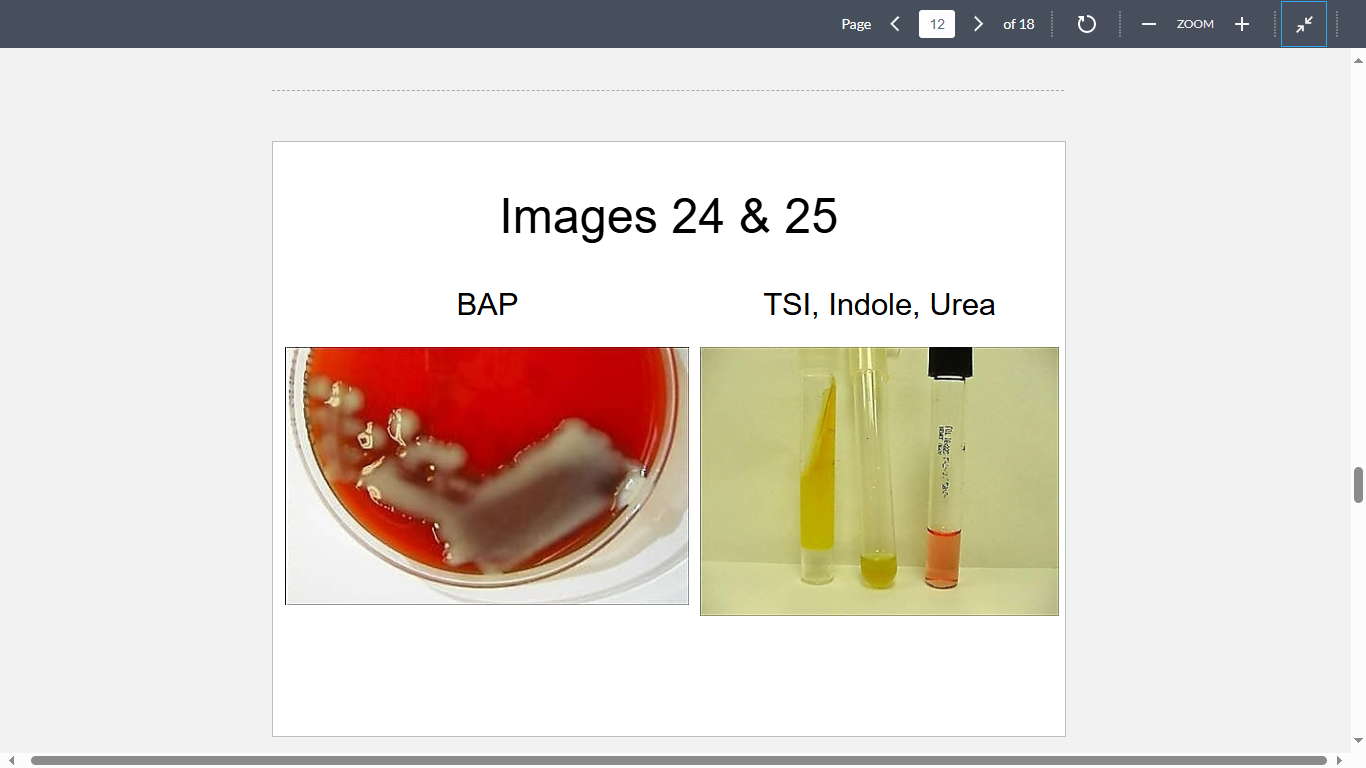
<p>A 40-year-old male is admitted to University Hospital with high fever, general malaise and respiratory distress. Laboratory testing reveals the patient has damage to both his kidneys and liver. A sputum sample reminiscent of “currant jelly” yields the following isolate (Images 24&25). Chest X-ray confirms the patient has a bilateral pneumonia. What is the most likely cause?</p>

1/49
Looks like no tags are added yet.
Name | Mastery | Learn | Test | Matching | Spaced | Call with Kai |
|---|
No analytics yet
Send a link to your students to track their progress

Questions 1-2 A five-year-old girl presents at University Hospital complaining of severe abdominal pain, nausea and vomiting, and frequent bloody diarrhea. The Attending Physician suspects hemolytic uremic syndrome and orders a colonoscopy and microbiological testing (Images 1&2) to confirm the diagnosis.
What organism is the most likely cause?
Enterohemorrhagic Escherichia coli

A five-year-old girl presents at University Hospital complaining of severe abdominal pain, nausea and vomiting, and frequent bloody diarrhea. The Attending Physician suspects hemolytic uremic syndrome and orders a colonoscopy and microbiological testing (Images 1&2) to confirm the diagnosis.
Which of the following contributes most to the pathogenesis of her kidney failure?
Endothelial cell damage due to Shiga toxin

A nine-year-old girl is experiencing pain in her right eye. Upon examination a corneal infiltrate with corneal edema was noted (Image 3). Corneal scrapings were cultured for bacteria and revealed the following organism (Images 4&5). What is the most likely cause?
Pseudomonas aeruginosa

A 58-year-old man was admitted to his local community hospital with a painful, swollen leg displaying massive denudation of the epithelium (Image 6). Upon questioning, the patient’s family recounted that the patient had cut himself while fishing in the Gulf of Mexico. A blood sample revealed the following organism (Image 7). Despite extensive treatment, the patient died on day 7 from multiple organ dysfunction. What organism is the most likely cause?
Vibrio vulnificus

A 2-year-old boy presents with skin lesions shown in Image 8. Specimens obtained from the lesions yielded this isolate (Images 9&10)
What is the most likely cause?
Group A streptococcus

A 2-year-old boy presents with skin lesions shown in Image 8. Specimens obtained from the lesions yielded this isolate (Images 9&10)
The patient is at risk for developing which of the following postinfectious sequelae?
Acute glomerulonephritis

This baby (Image 11) was born to a woman who had had no prenatal care. Culture of the discharge on Thayer-Martin agar grew an isolate that was oxidase positive and utilized glucose, but not maltose. Gram-stained smear of the isolate was likely to show which of the following microscopic morphologies?
Gram-negative diplococci

A 30-year-old man presents with the following nail condition (Image 12). Culture of the drained pus is shown in Image 13. Clumping test is positive. What is the most likely cause?
Staphylococcus aureus

A 70-year-old resident of a nursing home has developed fever, productive cough and difficulty breathing. His chest X-ray shows an area of consolidation in the right lower lobe of the lung. The patient’s sputum yields these organisms (Images 14&15). He is diagnosed with pneumonia, most likely caused by which of the following?
Streptococcus pneumonia
A 27-year-old pregnant woman has developed meningitis shortly after drinking raw milk at her grandparents’ farm. Gram stain of her CSF shows these organisms (Image 16). Culture of the CSF yields an isolate (Image 17) that produces barely noticeable beta- hemolysis. The isolate is most likely to be
Motile when incubated at room temperature, Catalase positive, CAMP positive, Able to replicate within eukaryotic cells

An outbreak of infectious diarrhea was reported from West Bengal, India, during the most recent monsoon season. Since June, a steady stream of deaths has been reported from Kolkata. More than a hundred people developed large volume watery diarrhea with “rice water” and died within hours. The most likely etiologic agent is depicted in Images 18&19. Which of the following factors may have contributed most to the pathogenesis of this disease?
Upregulation of the chloride channel by cholera toxin
A 47-year-old diabetic male has developed osteomyelitis of the fibula. Culture of a needle aspirate obtained from the infected bone yields these colonies on a MacConkey agar plate (Image 20). The isolate is subcultured on TSI, tryptone and urea containing media (Image 21). What is the most likely cause?
Salmonella enterica

Image 22 depicts the right lower extremity of a 14-year-old high school student whose history was remarkable for a case of Scarlet fever that had started six days prior to his hospitalization. At the time of admission, the patient was hypotensive, and not responsive to verbal communication. He also had diffuse rash and according to his mother, had not produced urine for at least 10 hours. His blood culture is shown in Image 23. Which of the following contributed most to his current condition?
Streptococcal pyrogenic exotoxin
A 40-year-old male is admitted to University Hospital with high fever, general malaise and respiratory distress. Laboratory testing reveals the patient has damage to both his kidneys and liver. A sputum sample reminiscent of “currant jelly” yields the following isolate (Images 24&25). Chest X-ray confirms the patient has a bilateral pneumonia. What is the most likely cause?
Klebsiella pneumoniae

This patient (Image 26) was first diagnosed with meningitis, followed by meningococcemia. Gram stain of a CSF sample yielded these organisms (Image 27). Despite appropriate management, he died of complications of diffuse intravascular coagulopathy, including Waterhouse-Friderichsen syndrome. On autopsy, he was found to have:
Necrosed adrenal glands

A 20-year-old man is diagnosed with severe otitis media accompanied by purulent drainage from the ear canal. Culture of the material yields bacteria with “musty basement” odor, depicted in Images 28 & 29. The isolate grows along the Staphylococcus aureus streak line when plated on blood agar. What is the most likely cause?
Haemophilus influenzae

A 35-year-old man presents with an epigastric pain, relieved by food intake. Endoscopy reveals numerous lesions in the gastric mucosa (Image 30). Biopsy of the adjacent tissue reveals the following organisms (Image 31)
What is the most likely cause?
Helicobacter pylori

A 35-year-old man presents with an epigastric pain, relieved by food intake. Endoscopy reveals numerous lesions in the gastric mucosa (Image 30). Biopsy of the adjacent tissue reveals the following organisms (Image 31).
The patient is at increased risk for developing which of the following?
Gastric carcinoma

Which of the following bacteria are known to invade cells through the mechanism depicted in Image 32?
Shigella sonnei and Listeria monocytogene

A 7-month-old boy was admitted to the PICU with elevated white blood count, was afebrile, and had a 2-cm open sore with surrounding erythema and induration that oozed 5 clear yellow fluid (Image 33). There was swelling and erythema of the entire arm. Upon questioning, the patient’s family recounted that the child had recently spent time at a wool sorting facility where his father was employed. Clinical biopsy of the infected site revealed the following organisms (Image 34). What organism is the most likely cause?
Bacillus anthracis

A 4-year old girl, who was on chemotherapy for her acute myelogenous leukemia, has developed severe neutropenia, fever and skin lesions (see Images 35 & 36). Cultures of the lesion and blood specimen yield organisms (Image 37) that are oxidase positive and produce fruity odor. What is the most likely diagnosis?
Ecthyma gangrenosum
A 3-year-old female was taken to Women’s and Children’s Hospital due to a persistent and severe cough which had lasted for two weeks. Initial blood work revealed elevated white blood cell counts consistent with infection. While at the clinic, the Physician Assistant noted the child had repeated bouts of coughing and difficulty catching her breath. The child’s father reported that his daughter often vomited after such coughing fits at home. A presumptive diagnosis of Whooping cough was made. Which of the following is NOT a virulence factor of the organism responsible?
Type IV pilus
A 12-year-old boy presents at the Green Meadows Clinic with fever, rash, low blood pressure and desquamation of the palms and feet. Physical examination reveals a cut on his right leg which has become infected. Blood cultures reveal the presence of a rapidly replicating beta hemolytic, Gram positive coccus arranged in chains. The physician makes a presumptive diagnosis of toxic shock syndrome.
What organism is the most likely cause?
Streptococcus pyogenes
Questions 23-24 A 12-year-old boy presents at the Green Meadows Clinic with fever, rash, low blood pressure and desquamation of the palms and feet. Physical examination reveals a cut on his right leg which has become infected. Blood cultures reveal the presence of a rapidly replicating beta hemolytic, Gram positive coccus arranged in chains. The physician makes a presumptive diagnosis of toxic shock syndrome.
Which of the following contributes most to the pathogenesis of his disease?
Massive activation of the T-cell population by a superantigen toxin
A 13-month-old infant presents at Children’s Hospital with rapid eye movement, uncoordinated muscle movement, and photosensitivity presenting as a rash on the skin. Urinalysis demonstrates the presence of elevated indolic compounds, confirming the clinical diagnosis of Hartnup disease. The elevated levels of indole derivatives within the infant’s urine are most likely related to catabolism of:
Unabsorbed tryptophan by colonic Escherichia coli
Several infants in a daycare center have developed self-limiting, non-bloody diarrhea. Stool cultures are positive for an identical strain of E. coli, which is most likely
EPEC
A 78-year old woman with a history of mitral valve stenosis dies of a congestive heart failure (CHF). She had a history of recurrent streptococcal pharyngitis as a child. What was the most likely underlying disease that resulted in her CHF?
Acute rheumatic fever
A 45-year-old Japanese man reports to the clinic complaining of abdominal cramps, nausea, vomiting, fever and chills. A patient history reveals the symptoms started several hours after consumption of freshly prepared sushi. Stool culture reveals comma-shaped Gram-negative bacteria that fail to ferment sucrose on a TCBS agar plate. He is managed symptomatically and fully recovers after 4 days. What is the most likely cause?
Vibrio parahaemolyticus
A 25-year-old teacher presented with a two day history of right hand swelling and fever. Two days prior to that, a stray dog bit him when he was trying to remove the dog from a classroom. The bite was deep into his hand, with two puncture wounds at the second and third web spaces, which were discharging pus. Culture of pus and tissue yielded pure growth of gram negative bacillus which stains bipolar. What is the most likely cause of the infection?
Pasteurella multocida
A 50-year-old man who had received an artificial heart valve developed an acute endocarditis. Blood cultures grew Gram-positive cocci in clusters that were found to be coagulase negative. What was the most likely cause?
Staphylococcus epidermidis
Neisseria gonorrhoeae infection of males often presents as urethritis with accompanying purulent discharge while females are generally asymptomatic. In each case, the type IV pilus plays an essential role in the pathogenesis of the organism. Which of the following functions does the pilus contribute to?
All of the above
Enterococcus faecalis and Group D streptococci can be differentiated from α-hemolytic (Viridans) streptococci based on which of the following?
Ability to grow in the presence of bile and convert esculin to esculitin
A 27-year-old Russian immigrant presents at an ER in New York City with sore throat, malaise, low grade fever and “bull neck”. Throat examination reveals a thick grey membrane covering part of the nasopharynx. Which of the following is involved in the pathogenesis of her disease?
Inhibition of elongation factor 2
A 40-year-old man has developed inflammation of the knees, ankles, feet and wrists, accompanied by conjunctivitis and frequent and painful urination. His history is unremarkable except for a diarrheal episode he had a few weeks earlier. Which of the following is known to be associated with his condition?
All of the above
A 25-year-old woman gives birth to a still baby. Her history is remarkable for a consumption of soft cheese at her baby shower. The patient’s blood and her baby’s autopsy specimens yield a Gram-positive coccobacillus that produces a narrow zone of β hemolysis on blood agar and is motile when incubated at 25 C. Which of the following factors is essential in the life cycle of the causative agent?
Listeriolysin O
A 5-year-old male is examined by his pediatrician after complaining of cough, nasal congestion, and moderate to severe ear pain. Direct visualization of the middle ear revealed extensive effusion and inflammation of the eardrum. Culture of purulent exudate revealed Gram-positive, alpha-hemolytic organisms which were sensitive to optochin and bile soluble. Based on available evidence the physician made a diagnosis of otitis media. What is the most likely cause?
Streptococcus pneumoniae
A 21-year-old man has developed diarrhea shortly after consuming reheated fried rice. What is the most likely cause?
Bacillus cereus
A 5-year-old boy is brought to the clinic because his parents are concerned about his “puffy” appearance and tea-colored urine. Examination reveals blood pressure of 140/100 mmHg. The boy’s history is remarkable for a recent episode of streptococcal pharyngitis. Acute glomerulonephritis is suspected, which has most likely resulted from
Immune complex deposition in the glomerular basement membrane
A newborn baby has developed acute meningitis. His blood culture was positive for Gram-positive cocci in short chains. The organism produced narrow zones of β hemolysis on blood agar and was catalase negative and CAMP positive. What was the most likely mode of the transmission?
While passing through the birth canal
A 15-year-old boy with cystic fibrosis has developed bacterial pneumonia. Sputum culture reveals blue-green colonies of grape-like odor. What is the most likely cause?
Pseudomonas aeruginosa
A 20-year-old woman presents to Student Health Center with complaints of frequent and painful urination. Her symptoms developed while she was on spring break with her boyfriend in Cozumel, Mexico. Her urine is positive for nitrites. Urine culture reveals significant bacteruria (105 bacteria/ml of urine) with Gram-negative rods that ferment lactose and produce indole. Which of the following is the most likely cause of her UTI
Escherichia coli
A 44-year-old female tourist from India is admitted to the local community hospital after complaining of mild fever, general malaise, sore throat, and difficulty breathing. Physical examination reveals swelling of the lymph nodes in the neck accompanied by a grey colored pseudomembrane obstructing the airway. Culture of throat swabs identified an organism which produces characteristic black colonies when grown on Tinsdale agar. The patient is in danger of developing which of the following complications?
Neurologic seizures and cardiac infarction
A 70-year-old patient is admitted to the VA (Veterans Administration) Hospital with cough, difficulty breathing and chest pain. Legionella pneumophila is recovered from his sputum. Which of the following mechanisms helps L. pneumophila to resist intracellular killing by macrophages?
Inhibition of phagolysosomal fusion
A 42-year-old man has developed diarrhea with fever and abdominal pain following consumption of grilled chicken. After 48-hour incubation at 42 C, his stool culture grows motile, comma-shaped, microaerophilic organisms. What is the most likely cause?
Campylobacter jejuni
A 42-year-old man has developed diarrhea with fever and abdominal pain following consumption of grilled chicken. After 48-hour incubation at 42 C, his stool culture grows motile, comma-shaped, microaerophilic organisms.
Three weeks later, the patient described in the preceding scenario develops weakness in his legs and arms and difficulty speaking, which is most likely:
Antibody mediated
A 25-year-old patient presented with pain in her left lower abdominal quadrant. Pelvic examination revealed cervical exudate and tenderness in the left adnexa (uterine appendages), and the patient was diagnosed with PID (pelvic inflammatory disease). Gram stain of the exudate revealed numerous organisms, which appeared as red kidney beans facing each other. The organism was later recovered on Thayer-Martin and chocolate agar media. Which of the following plays the most important role in virulence of the isolated pathogen?
Type IV pilus
A 57-year-old female undergoing chemotherapy is admitted to the ER by her primary physician after complaining of a dry cough, fever and chills, general muscle pain, and severe headache. Despite appropriate medical care, the patient died within 48 hours due to multiple organ failure resulting from septic shock. Autopsy revealed the patient had contracted bacterial pneumonia. Culture of lung aspirates on buffered charcoal yeast extract agar grew a motile Gram-negative bacillus. Colonies had a characteristic ground glass appearance. What is the most likely cause?
Legionella pneumophila
A 4-month-old male infant was brought to the pediatrician because of coughing and choking spells for two weeks. At the end of a coughing spell, the baby often vomited and had difficulty catching breath. On the morning of the visit, the mother noticed that his lips were blue at the end of a coughing spell. The mother related that she had also experienced coughing spells followed by choking and vomiting for three weeks. She had received a course of amoxicillin without relief. On evaluation, the baby's temperature was 37.7 C (); pulse, 200/min (); respiration, 72/min (); WBC, 140,000/mm3 () of which 50% were lymphocytes (). Chest X-ray was suggestive of pneumonia. What is the most likely etiologic agent?
Bordetella pertussis
A 37-year-old male presents at the Green Meadows Clinic complaining of fever, acute joint pain, skin nodules and shortness of breath accompanied by chest pains. Medical History revealed the patient had been diagnosed with streptococcal pharyngitis several days previously. The physician makes a presumptive diagnosis of acute rheumatic fever.
What is the most likely explanation for the patient’s condition?
Immune complex deposition on endothelial cell membranes
A 37-year-old male presents at the Green Meadows Clinic complaining of fever, acute joint pain, skin nodules and shortness of breath accompanied by chest pains. Medical History revealed the patient had been diagnosed with streptococcal pharyngitis several days previously. The physician makes a presumptive diagnosis of acute rheumatic fever.
The development of acute rheumatic fever is an example of which of the following?
Type II Hypersensitivit